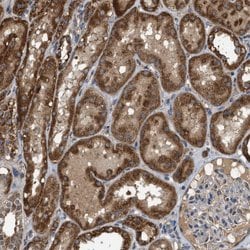

Promotional price valid on web orders only. Your contract pricing may differ. Interested in signing up for a dedicated account number?
Learn More
Learn More
Invitrogen™ NAPE PLD Polyclonal Antibody


Rabbit Polyclonal Antibody
Supplier: Invitrogen™ PA554092
Description
Immunogen sequence: MKYQHVDPEE AVRIHTDVQT KKSMAIHWGT FALANEHYLE PPVKLNEALE RYGLNAEDFF VLKHGESRYL NNDDE Highest antigen sequence identity to the following orthologs: Mouse - 85%, Rat - 85%.
N-Acylphosphatidylethanolamine (NAPE)-hydrolyzing phospholipase D (NAPE-PLD) is a membrane-bound enzyme which releases the endocannabinoid anandamide and other bioactive N-acylethanolamines from their corresponding NAPEs in animal tissues. NAPE-PLD has been shown to be expressed by specific populations of neurons in the brain and targeted to axonal processes. Recent studies have suggested that NAEs generated by NAPE-PLD in axons may act as anterograde synaptic signaling molecules that regulate the activity of postsynaptic neurons. NAPE-PLD has also been shown to catalyze the hydrolysis of NAPE to generate OEA (oleoylethanolamide), a natural lipid amide that inhibits food intake in free-feeding rodents by prolonging latency to feed and postmeal interval.
Specifications
| NAPE PLD | |
| Polyclonal | |
| Unconjugated | |
| NAPEPLD | |
| A530089G06; C7orf18; DKFZp781D1098; FMP30; Mbldc1; Metallo-beta-lactamase domain containing 1; N-acyl phosphatidylethanolamine phospholipase D; N-acyl-phosphatidylethanolamine-hydrolyzing phospholipase D; NAPE-hydrolyzing phospholipase D; NAPEPLD; NAPE-PLD | |
| Rabbit | |
| Antigen affinity chromatography | |
| RUO | |
| 222236 | |
| Store at 4°C short term. For long term storage, store at -20°C, avoiding freeze/thaw cycles. | |
| Liquid |
| Immunohistochemistry (Paraffin), Immunocytochemistry | |
| 0.3 mg/mL | |
| PBS with 40% glycerol and 0.02% sodium azide; pH 7.2 | |
| Q6IQ20 | |
| NAPEPLD | |
| Recombinant protein corresponding to Human NAPEPLD. Recombinant protein control fragment (Product #RP-92784). | |
| 100 μL | |
| Primary | |
| Human | |
| Antibody | |
| IgG |
Product Content Correction
Your input is important to us. Please complete this form to provide feedback related to the content on this product.
Product Title
Spot an opportunity for improvement?Share a Content Correction